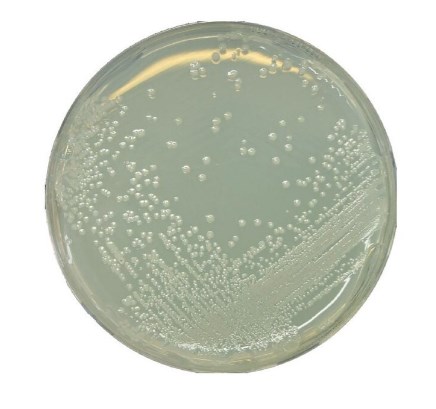

Description
Synonyms: Alicyclobacillus selective agar, Bacillus acidoterrestris agar
General description
GranuCult® BAT agar supports the growth of Alicyclobacillus spp. These are aerobic, Gram-positive spore-forming bacteria, with optimum growth at low pH and increased temperatures. Alicyclobacilli are spoilage organisms, especially affecting the quality of fruit juices.
GranuCult® BAT agar contains glucose as a carbon and energy source. Yeast extract is the source of vitamins, particularly the B-group. Potassium dihydrogen phosphate acts as a buffering system. The low pH and the high incubation temperature inhibit the contaminating flora. This medium contains many trace elements, which supply the specific requirements of the Alicyclobacillus spp. agar is the solidifying agent however, the gel strength is weak due to low pH.
GranuCult® BAT agar contains glucose as a carbon and energy source. Yeast extract is the source of vitamins, particularly the B-group. Potassium dihydrogen phosphate acts as a buffering system. The low pH and the high incubation temperature inhibit the contaminating flora. This medium contains many trace elements, which supply the specific requirements of the Alicyclobacillus spp. agar is the solidifying agent however, the gel strength is weak due to low pH.
Application
GranuCult® BAT agar is suitable for the enumeration, detection, and identification of Alicyclobacillus spp. from fruit juices, other beverages, and their ingredients, environmental samples, including process water and other materials in the area of food production and food handling.
PROPERTIES
Agency
according to IFU 12
form
medium granules (dehydrated (DCM))
packaging
pkg of 500 g
manufacturer/tradename
GranuCult®
storage condition
protect from light (both UV and Sun light)
technique(s)
microbiological culture: suitable
application(s)
food and beverages
microbiology
storage temp.
15-25°C
suitability
Alicyclobacillus spp. (spp.)

Reviews
There are no reviews yet.